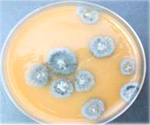

Avanzato, M.V. and C.S. Rothrock. 2010. Use of Selective Media and Baiting to Detect and Quantify the Soilborne Plant Pathogen Thielaviopsis basicola on Pansy.
The Plant Health Instructor. DOI: 10.1094/PHI-I-2010-0610-01
HYPOTHESIS:
The nursery industry plays an important role in the distribution of the soilborne pathogen
Thielaviopsis basicola (Berk. & Broome) Ferraris (syn.
Chalara elegans Nag Raj & Kendrick), the causal agent of black root rot, by the sale of diseased pansies (Viola × wittrockiana Gams ex Kappert) and associated infested potting media.
CLICK HERE FOR INSTRUCTOR'S NOTE 1
OBJECTIVES:
- To detect the presence of black root rot and
T. basicola on pansies.
- To assay potting media containing pansies or soil from plant beds in the landscape for
T. basicola using a selective medium and baiting techniques.
INTRODUCTION:
Soilborne pathogens have developed the ability to survive in soil for extended periods after host crop residues have decomposed, a situation where many foliar plant pathogens lose viability. In the absence of a host, soilborne pathogens survive by one or more of the following mechanisms:
- Soilborne pathogens may be facultative parasites, spending much of their life growing saprophytically or reproducing on a previously diseased host, decomposing plant debris, or other organic matter.
- Soilborne pathogens may produce resistant survival propagules such as oospores (Phytophthora, Pythium), sclerotia (Rhizoctonia, Sclerotinia, Sclerotium, Verticillium,) or chlamydospores (Fusarium, Phytophthora, Thielaviopsis).
- Soilborne pathogens often have wide host ranges and may be parasites on weeds, volunteer plants, or other crops.
A soilborne pathogen maintains itself by one or more of these mechanisms if it is to be successful (Figure 1).

Figure 1 |
|
Common symptoms of diseases caused by soilborne pathogens include seed rot, damping-off [defined as the death of developing seedlings before emergence (pre-emergence damping-off) or after emergence from the soil surface (post-emergence damping-off)], root rot, crown or collar rot, vascular wilt, and rots of bulbs, corms, fruit, and tubers. Observation of the initial symptoms of root disease and the detection of associated pathogens is difficult due to the soil matrix around the roots.
In addition to plant pathogens, the soil is home to a vast array of other organisms; algae, bacteria (including actinomycetes), earthworms, fungi, insects, mites, nematodes, oomycetes, and protozoa may influence the activity of the pathogen and complicate its isolation. By far, the most common groups of soilborne pathogens are nematodes and filamentous eukaryotic organisms (oomycetes and fungi) such as
Phytophthora, Pythium, Fusarium, Rhizoctonia, Sclerotinia, Sclerotium, Thielaviopsis, and
Verticillium. However, bacterial pathogens, such as
Agrobacterium tumefaciens, Ralstonia solanacearum, and
Streptomyces scabiei are also considered soilborne.
Movement of soilborne pathogens is limited because their inoculum and growth occurs primarily in the soil. Dissemination of soilborne pathogens in the field or landscape or from location to location depends on the movement of infested soil/potting media, plant residue, or colonized plant material. Spread of soilborne pathogens in large part is a result of the activities of man. These activities may include irrigation, tillage practices, movement of equipment among fields, and in many cases, the movement and sale of plants or plant parts, especially vegetatively propagated crops.
To study soilborne pathogens, researchers generally isolate the pathogen from the soil to determine their presence or estimate their population. Pathogens can be recovered from soil by:
-
Direct plating – Soil is directly placed on a culture medium (usually a selective medium) and observed for colony development characteristic of the organism.
-
Dilution plating (Figure 2) – A specified volume of potting media or soil is mixed with a sterile liquid until the substrate is in suspension. A known volume of the suspension is then pipetted into a volume of a sterile liquid to obtain a dilution series. From each dilution, a known volume is pipetted onto plates of a culture medium (usually a selective medium) and incubated to allow growth of the pathogen. Characteristic colonies should develop from one or several of the dilutions prepared, depending on the density of the organism in the soil. This method is useful for quantifying microorganisms in soil

Figure 2
|
|
-
Trapping or baiting – A piece of plant tissue is placed in contact with the soil and incubated for a period of time to allow the pathogen of interest to grow into the bait. The plant tissue used as a bait is usually recovered and placed on a culture medium. This technique takes advantage of the parasitic nature of the pathogen permitting it to be separated from the vast number and diversity of other organisms in the soil by its preferential growth into the plant tissue.
Thielaviopsis basicola is a soilborne pathogen that causes disease on over 200 plant species (CAB International; Johnson, 1916; Otani, 1962; Shew and Meyer, 1992). Economically important plant species include field crops, such as cotton and several legumes, and ornamental plants, including pansy, poinsettia, and holly. This pathogen produces two types of asexual spores: clear cylindrical endoconidia and chains of dark, thick-walled chlamydospores, also known as aleuriospores (Figure 3). The pathogen may survive for years as chlamydospores in the absence of a host plant or parasitically on other plants that are hosts. Symptoms on hosts are a black cortical rot of the roots that stunts plant growth, thus delaying development and reducing yield (Figure 4). Generally this disease is a chronic problem, rarely killing the host.

Figure 3 |

Figure 4 |
|
T. basicola is easily baited from soil or plants by placing the material on carrot disks (Yarwood, 1946). This pathogen also may be isolated using the selective medium TB-CEN (recipe below), which contains carrot juice as a nutrient source and ingredients to inhibit the growth of bacteria, oomycetes, and other fungi (Specht and Griffin, 1985).
|
Modified TB-CEN medium for the isolation of
Thielaviopsis basicola |
|---|
|
Materials per liter |
| • Agar | 12 g |
| Autoclave and cool to 45°C, then add: |
| • CaCO3 | 1.0 g |
| • Streptomycin sulfate | 0.50 g |
| • Penicillin G | 60 mg |
| • Chlortetracycline HCly | 30 mg |
| • Nystatinz | 250,000 units |
| • Etridiazole (e.g., Koban 30WP) | 400 mg a.i. |
| • Fresh carrot juice | 80 ml |
| • Adjust pH to 5.3 with H2SO4 | |
y Place chlortetracycline in 5 ml of water, add 5N NaOH (approx. 2 drops) until dissolved
z Dissolve nystatin in approximately 2 ml of ethanol |
CLICK HERE FOR INSTRUCTOR'S NOTE 2
In this laboratory exercise we will examine if the sale of pansy plants in the fall or spring is important to the spread of
T. basicola on diseased plants or in infested potting media. By observing symptoms and signs on the host and comparing baiting techniques and selective media, the class should be able to prove or reject this hypothesis.
MATERIALS (per group):
CLICK HERE FOR INSTRUCTOR'S NOTE 3
- Soil or potting medium from: a) pansies for sale and b) a landscape site.
- Gallon-size resealable plastic bags
- Forceps
- 2 Erlenmeyer flasks (500 ml)
- 2 tablespoons or small beakers
- Graduated cylinder
- Pipettor (P-1000) and a box of sterile pipet tips (1000 µl)
- 100 mm Petri plates
- Sterile water agar (0.1% agar)
- Molten TB-CEN medium
- Molten potato-dextrose agar (PDA)
- Filter paper disks (Whatman #4)
- Wrist-action shaker
CLICK HERE FOR INSTRUCTOR'S NOTE 4
PROCEDURES
Each group should select a pot or six-pack of pansies and a bag of soil from a landscape site. Note the source of the pansies (nursery or retail store) and landscape soil (flower bed or turfgrass).
Presence of Black Root Rot and
Thielaviopsis basicola on Pansy (Figure 5)
- Carefully remove the pansies obtained from each source from the pots. Gently shake off potting medium from the roots into a resealable plastic bag. Use a separate bag for each source.
- Soak or wash roots under running tap water to remove remaining potting medium.
- Observe the roots for symptoms of black root rot (Figure 6) and presence of chlamydospore chains of
T. basicola (Figure 7) using a stereomicroscope, and finally as a squash mount in water on a microscope slide under a compound microscope.
- Record the presence or absence of symptoms and signs for each sample.

Figure 5 |

Figure 6 |

Figure 7 |
CLICK HERE FOR INSTRUCTOR'S NOTE 5
Assay for
Thielaviopsis basicola using Selective Media and Baiting
- Thoroughly mix the potting medium or landscape soil within their respective plastic bags.
- Remove an equal volume (two level tablespoons or 30 cm3) of potting medium and soil from each sample and place each sample in a separate 500 ml Erlenmeyer flask. Use a different tablespoon for each sample.
- Using a graduated cylinder, measure a volume of sterile dilute water agar to bring the volume in a flask to 300 ml, a 1/10 dilution (approximately 295 ml for potting medium or 280 ml for soil).
- Pour the sterile dilute water agar from the graduated cylinder into each 500 ml flask containing a soil or potting medium sample.
- Place the flasks on a wrist-action shaker.
CLICK HERE FOR INSTRUCTOR'S NOTE 6
Dilution Plating – Pour-plate Technique (Figure 8)
- Shake samples for 15 minutes to disrupt potting medium or soil and suspend any fungal propagules.
- For each flask, pipette 1 ml of potting medium/soil suspension into the bottom of each of five Petri plates. Change tips between samples.
- Pour 25 to 30 ml of molten (approximately 45°C) TB-CEN medium into the bottom of each Petri plate. Gently swirl the plates until the sample is dispersed.
- To demonstrate the selectivity of the TB-CEN medium, pipette 1 ml of suspension from one of your samples into a second set of five Petri plates and pour molten PDA into the plates.
- Incubate the plates at room temperature in the dark. Check the plates 7 and 14 days after plating for fungal colonies. Colonies of
Thielaviopsis basicola are characterized as grey to black compact colonies (Figure 9>).
- Record the number of colonies of
T. basicola per plate of TB-CEN medium. Estimate the total number of colonies in the plates with PDA and note if any of these colonies appear to be
T. basicola.

Figure 8 |
Figure 9 |
Baiting: Carrot Disk Assay (Figure 10)
- Prepare 10 carrot disks by slicing a peeled carrot into 5 mm thicknesses.
- Lightly press each carrot disk onto the surface of the soil or potting medium in the plastic bags using forceps. Remove the disks and place them soil-side up into a Petri plate lined with moist filter paper. Prepare two Petri plates with five disks of carrots per plate for each sample.
- Incubate the plates at room temperature. Check periodically to ensure that there is sufficient water to maintain a moist environment. Water can be added directly to the filter paper or sprayed onto the carrot disks if the plates become too dry.
- Check plates 7 and 14 days after plating for growth of
T. basicola (Figure 11).
- Record your results as the proportion of carrot disks with growth of
T. basicola.

Figure 10 |

Figure 11 |
DATA COLLECTION:
- Record the presence or absence of disease symptoms and signs of the pathogen on each pansy sampled.
- Record the number of colonies of
T. basicola per Petri plate for each sample 7 and 14 days after starting the laboratory exercise (Figure 9).
- Record number of carrot disks with
T. basicola for each sample (Figure 11).
- Set up a data sheet of results for your group and the class similar to the tables provided below:
CLICK HERE FOR INSTRUCTOR'S NOTE 7
CLICK HERE FOR EASILY PRINTABLE DATA TABLES
QUESTIONS:
- Did you find differences among nurseries with respect to the presence of
T. basicola? Should you be concerned about where you buy your pansies?
- Was examining the plants for disease as effective as using soil assays to detect the pathogen?
- Can baiting and dilution plating both be used to detect
T. basicola? What are the advantages or disadvantages of each method? Is the TB-CEN medium a good selective medium?
- What are possible sources for the introduction of the pathogen into nursery operations? How would you suggest managing this problem?
- Was the pathogen detected in landscape settings and if so, was it associated with planting of annuals?
- Were your results similar to the other groups; if not why not?
Additional Questions
- Do you think that nurseries are aware of potential problems with black root rot on pansy?
- What is the responsibility of the nursery or retail outlet for providing disease-free plants?
- What would be an acceptable cost for providing disease-free plants?\
Get the Answers to these QuestionsLITERATURE CITED
- CAB International. 2001.
Thielaviopsis basicola. Crop Protection Compendium. CAB International, Wallingford, UK.
http://www.cabicompendium.org/cpc.
- Copes, W.E., and Stevenson, K.L. 2008. A pictorial disease severity key and the relationship between severity and incidence for black root rot of pansy caused by
Thielaviopsis basicola. Plant Disease 92:1394-1399.
- Johnson, J. 1916. Host plants of
Thielavia basicola. Journal of Agricultural Research 7:289-300.
- Otani, Y. 1962. Studies on the black root rot disease caused by
Thielaviopsis basicola (Berk. & Br.) Ferris. Bulletin Okayama Tobacco Experiment Station, 23:1-118.
- Shew, H.D., and Meyer, J.R. 1992.
Thielaviopsis. Pages 171-174 in: L.L. Singleton, J.D. Mihail, and C.M. Rush, eds. Methods for Research on Soilborne Phytopathogenic Fungi. APS Press, St. Paul, MN.
- Specht, L.H., and Griffin, G.J. 1985. A selective medium for enumerating low populations of
Thielaviopsis basicola. Canadian Journal of Plant Pathology 7:438-441.
- Yarwood, C.E. 1946. Isolation of
Thielaviopsis basicola from soil by means of carrot disks. Mycologia 38:346-348.
